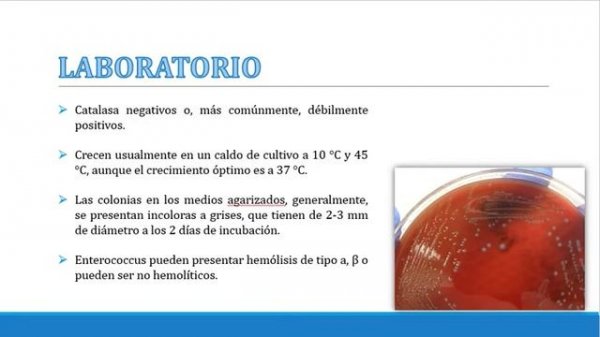
ENTEROCOCCUS FAECALIS 1

Найдено результатов: 100
Enterasnexus

Травматический Colt 1911 или Техкрим ТК1911Т

Выживаем в мире МАЙНКРАФТ вместе с Крисом

первый фильм амогусов

Энрики эглейсес

Good time 100% By Gepsoni4 Наконец-то

Pissing Enthusiasts

ГОРНИЧНАЯ / THE HOUSEMAID (2025) Самопознание через кино. Разбор, обзор, анализ, рецензия, отзыв

Double Dimension By GirlyAle02 HARD *⭐ 5* Geometry Dash 2.2

Enterococcus faecalis.

ENTEROCOCCUS FAECALIS

Прохождение Back on Track для Lemax-а

GEOMETRY DASH
ENTEROCOCCUS FAECALIS 1

Nikos Vertis - An Eisai Ena Asteri

Enigma - Хиты. Энигма лучшее 90

Enterococcus faecalis

Эннио Морриконе. Одинокий пастух.

Dimensional Collapse Hard 5 (ЗВЁЗД) Complete 1 Coin No Song Потому что No internet

Моя вторая худшая Смерть в GD на этот раз Blast Processing (Прочитайте описание)

Обзор Enya Nova Go Sonic на русском. Электрогитара с динамиком и встроенным процессором.
![Polargest by Robtop я Derus [GD]](https://pic.rtbcdn.ru/video/2025-08-22/f4/12/f412a01e6e178339a53e0652427fa370.jpg?width=640)
Polargest by Robtop я Derus [GD]

РАЗОБЛАЧЕНИЕ НЯНИ из DEEP WEB !

Энтеролактис

Enterococcus y Resistencia Bacteriana